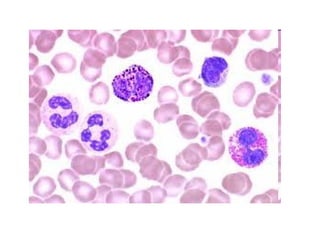
El cor i la sang

More Related Content
PPT
PPT
PPT
PPT
PPT
PPT
PPTX
La Reproducció (Fil Eminimizer) PPT
More from lacustariainicial
PPT
PPT
PPT
PPT
PPT
Projecte dinosaures de 2n PPT
ODP
Experiment dissecció del verat ODP
ODP
ODP
PPT
El cor i la sang
- 1.
- 7.
A
CUL
U RÍ
A
L E
A IC
UL NTR
C
U RÍ VE
A
LE
IC
NTR
VE